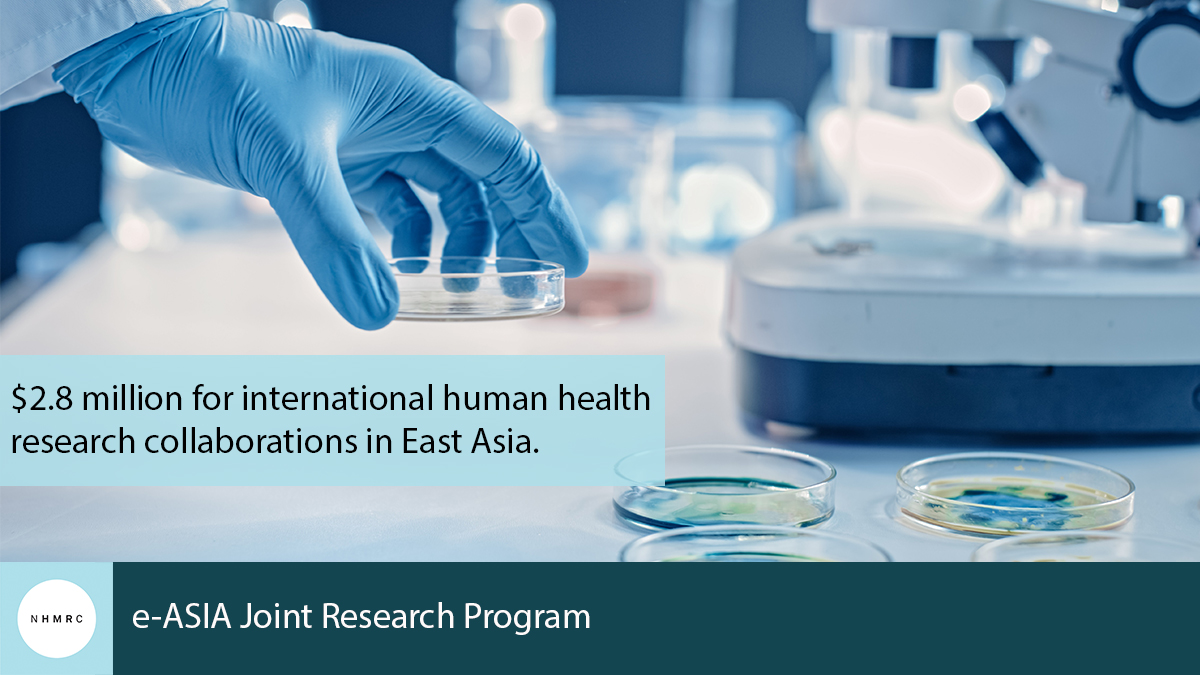
NHMRC (@nhmrc) on Twitter photo #NHMRC welcomes the announcement by @GregHuntMP of more than $2.8 million to support international collaborations in health and medical research through NHMRC's participation in the e-ASIA Joint Research Program. 👉
bit.ly/3rb49E0 #NHMRC welcomes the announcement by @GregHuntMP of more than $2.8 million to support international collaborations in health and medical research through NHMRC's participation in the e-ASIA Joint Research Program. 👉
bit.ly/3rb49E0

Paul Agius
@paulaagius2
Associate Professor Biostatistics, Deakin University
ID: 1172022746521333760
https://burnet.edu.au/people/329_paul_agius 12-09-2019 05:43:02
34 Tweet
69 Followers
120 Following




Village distributed topical repellent can protect from Pf #malaria infection. On #WorldMosquitoDay we share our trial findings in PLOS Medicine. Thrilled to be a part of this significant work. Burnet Institute BurnetMalaria ACREME

Congratulations Burnet Institute on your #research findings that insect repellent has real-world effectiveness against #malaria. An important finding that could see World Health Organization (WHO) endorse the deployment of repellents for malaria prevention in places like Myanmar. burnet.edu.au/news/1285_inse…

Paul Agius and colleagues study the use of a topical insect repellent in Myanmar for protection against malaria in their latest publication PLOS Medicine doi.org/10.1371/journa… .Burnet Institute .University of Melbourne #malaria


EVE-M brings together world leading experts in #bacterialvaginosis STIs #contraception & #pretermbirth. Prof Gilda is excited by this golden opportunity to transform women's sexual & #reproductivehealth eve-m.com @GregHuntMP AusBiotech @biomelb The Alfred

"New South Wales isn't the gold standard. New South Wales is lucky." — Norman Swan on the coronavirus responses between states



Congratulations Julie Simpson! You provide guidance and inspiration to so many of us in the ACREME network and beyond. 🤩🥳🤩

Great piece by Prof Brendan Crabb and Mike Toole Burnet Institute Go for Gold and Reunite the Australian community! Victoria is right to be cautious in exiting stage four theage.com.au/national/victo…

Why aim for zero mystery cases? Australia desperately needs to get back to being a nation. Huge social and economic reasons too. No community #COVID19 transmission is the best pathway to achieve that acc to Professors Prof Brendan Crabb @mtoole47. burnet.edu.au/news/1315.





Integration and implementation of sample collection for molecular and serological surveillance of #malaria into networks of village health volunteers servicing hard-to-reach populations in the Mekong region Freya Fowkes bmcmedicine.biomedcentral.com/articles/10.11…

Check-out our on-demand symposium presentation for #WCEpi2021 'Applying novel multi-disciplinary methods to accelerate malaria elimination'. Paul Agius, Dr. Saber Dini, Prof. Julie Simpson, Dr. Tasmin Symons and Dr. Angela Devine. ACREME BurnetMalaria Burnet Institute